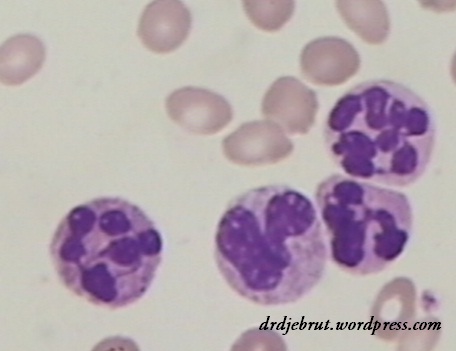
neutrofil hipersegmentasi
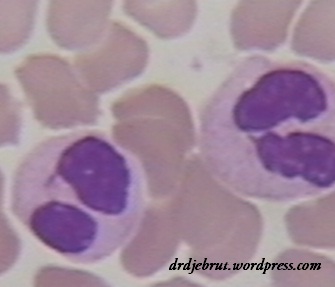
kelainan Pelger Huet

Sindroma Mielodisplasia atau MDS
Tidak terasa sudah sekitar 6 bulan blog ini saya telantarkan karena “kesibukan” main-main dengan si kecil yang baru saja lahir bulan Januari lalu 🙂 Untuk mengawali lagi, saya coba menulis tentang Sindroma Mielodisplasia atau biasa disebut MDS (Myelodysplastic Syndrome) yang kebetulan beberapa waktu lalu diminta oleh salah satu pembaca.
MDS merupakan suatu kumpulan kelainan dari sel punca (stem cell) darah yang ditandai dengan terganggunya proliferasi dan pendewasaan sel hematopoiesis. Sebagian besar sindroma ini mengenai penderita berumur lebih dari 50 tahun. Namun di RSSA Malang pernah juga saya jumpai pada pasien yang lebih muda. Penyebab MDS ini masih belum diketahui. Kemungkinan karena paparan bahan kimia atau akibat radioterapi dan kemoterapi penyakit yang lain.
Karakteristik dari MDS adalah hematopoiesis (pembentukan sel darah) yang tidak efektif dan adanya displasia sel punca akibat proliferasi dan maturasi yang abnormal. Dua karakteristik inilah yang menyebabkan terjadinya anemia, leukopenia, dan/atau trombositopenia pada penderita MDS. Gejala dan tanda klinis yang dialami merupakan akibat dari turunnya jumlah sel darah, yaitu lemah lesu dan sesak (karena anemia), rentan terhadap infeksi (karena leukopenia), dan rentan terhadap perdarahan, ptekiae, purpura, ekimosis (karena trombositopenia). Meningkatnya resiko kematian pada MDS terutama karena perdarahan dan infeksi. Selain itu, penderita MDS memiliki resiko yang lebih tinggi untuk berkembang menjadi leukemia akut.
Gambaran laboratorium yang biasa ditemukan adalah turunnya kadar Hb, jumlah leukosit, dan jumlah trombosit. Sebagian besar pasien menunjukkan gambaran eritrosit yang makrositik (MCV>102). Jumlah leukosit bisa saja normal atau turun dengan disertai perubahan displasia seperti netrofil hipogranulasi, hiposegmentasi, fragmentasi inti dan kelainan Pelger-Huet. Sedangkan jumlah trombosit bisa normal atau turun, namun dengan riwayat perdarahan yang berlebihan pada cedera yang ringan, menunjukkan telah terjadi kelainan fungsi trombosit.
gb 1. neutrofil hipersegmentasi
gb 2. kelainan Pelger Huet
BMP (pungsi sumsum tulang) merupakan standar baku emas dalam mendiagnosa MDS, terutama di Indonesia, karena analisa sitogenetik maupun pemeriksaan imunofenotipe hanya tersedia di beberapa RS saja dan harganya pun masih mahal. Pada gambaran sumsum tulang dapat dijumpai gambaran sel yang hiperseluler dengan jumlah aktifitas hematopoiesis yang masih baik, berlawanan dengan temuan di darah tepi yang terjadi penurunan jumlah sel. Hal ini menunjukkan adanya ketidakefektifan hematopoiesis. Juga dapat ditemukan berbagai kelainan bentuk sel dan perubahan megaloblastik, seperti binukleasi, internuclear bridging, dan karyorrhexis pada seri eritrosit; neutrophil hipersegmen, hiposegmen, hipogranular, dan giant stab pada seri granulosit; dan hipo/hiperlobulasi dan mikromegakariosit pada seri megakariosit.
gb 3. binukleasi
gb 4. internuclear bridging
gb 5. neutrofil hipogranulasi
gb 6. mikromegakariosit dan hipolobulasi
Pengobatan standar pada pasien MDS di Indonesia terutama adalah terapi suportif untuk mengatasi anemia dan trombositopenia, yaitu dengan transfusi sel darah merah dengan PRC dan transfusi trombosit. Juga dapat diberikan kemoterapi dengan dosis rendah. Sedangkan di negara maju sudah dilakukan transplantasi sumsum tulang, yang dikatakan sebagai pilihan terapi yang utama.
Semoga bermanfaat
Sumber: Manual of Clinical Hematology